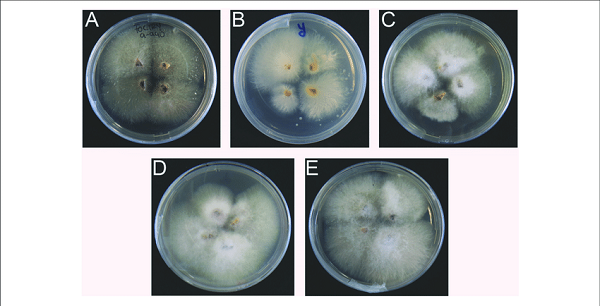

Bệnh vàng lá Panama là căn bệnh có sức tàn phá nghiêm trọng đến vườn chuối. Đồng thời, căn bệnh này cũng ảnh hưởng năng suất và chất lượng nông sản. Vì vậy, bài viết sau đây phanthuocvisinh.com sẽ giới thiệu chi tiết về cây chuối bị bệnh vàng lá nhằm mục đích giúp bạn chủ động nhận biết và phòng chống căn bệnh này.
Contents
Bệnh cây chuối vàng lá có tên gọi là bệnh héo rũ Panama hoặc bệnh vàng lá Panama. Nguyên nhân khiến cây chuối mắc bệnh héo rũ Panama là do nấm Fusarium oxysporum f. sp. Cubense.
Nấm Fusarium oxysporum f. sp. Cubense khiến cây chuối bị vàng lá
Thông thường, cây chuối bị bệnh vàng lá thì dấu hiệu nhận biết đầu tiên và dễ thấy nhất là lá cây sẽ từ từ chuyển sang màu vàng. Hiện tượng này bắt đầu ở lá già sau đó lan lên các lá non. Phần bìa lá sẽ mất màu xanh và chuyển vàng trước sau đó lây lan dần vào phía gân lá.
Cây chuối bị bệnh có lá héo rũ và cuống lá bị gãy. Vì vậy, lá cây phải treo trên thân giả. Khi bệnh vàng lá phát tác, lá già héo khô sẽ treo quanh thân giả. Một số đọt có thể mọc thẳng nhưng chúng bị biến dạng và mất màu xanh mà thay vào đó là màu vàng.

Dấu hiệu cây chuối mắc bệnh vàng lá Panama
Nếu tình trạng bệnh kéo dài thì các bẹ phía ngoài bị nứt dọc. Chồi non phát triển nhưng cũng nhanh chóng bị héo rũ. Nếu bạn cắt ngang thân sẽ thấy bó mạch có màu nâu vàng và bốc mùi hư thối. Lúc này, cây thật ra đã chết hẳn rồi nhưng thân vẫn chưa bị đỗ ngã.
Bệnh héo rũ Panama thường xuất hiện ở cây chuối từ 3 năm tuổi trở lên. Đặc biệt, bệnh này phát triển mạnh mẽ trong giai đoạn cây chuối ra hoa và đậu quả non. Các vùng trồng chuối càng lâu năm thì tỷ lệ mắc căn bệnh này càng cao.
Như đã nhắc đến ở phần trên, cây chuối mắc bệnh vàng lá sẽ chết dần. Lá cây sẽ chuyển dần sang vàng từ lá giá đến lá non. Các đọt non dù có thể phát triển từ thân nhưng cũng nhanh chóng bị héo rũ.

Tác hại của bệnh héo rũ vàng lá chuối
Điều này sẽ không có gốc để lưu cho mùa vụ sau hoặc trồng tiếp cây mơi. Đặc biệt, cây bị bệnh thì năng suất thu hoạch cũng giảm hẳn, chất lượng nông sản kém. Hơn nữa, một cây bị bệnh có thể lây lan cho các cây khác. Nếu nghiêm trọng có thể lây lan khắp khu vực trồng chuối.
Căn bệnh này dù nguy hiểm gây hại cho cây chuối cũng như gây tổn thất cho người nông dân. Tuy nhiên, nếu bạn chủ động có những biện pháp phòng ngừa thì vẫn có thể đẩy lùi căn bệnh này.

Biện pháp phòng trừ bệnh héo vàng lá chuối
Đầu tiên, bạn cần kiểm tra và rà soát thật kỹ chuối giống. Bởi trong quá trình vận chuyển từ nơi này đến nơi khác, chắc hẳn cây không tránh khỏi việc bị lây lan bệnh. Ngoài ra, một số nguồn cung kém uy tín cung cấp chuối giống chất lượng thấp bị mắc bệnh. Do đó, việc kiểm tra chuối giống trước khi trồng rất quan trọng.
Bên cạnh đó, bạn cũng cần khử trùng thật sạch quần áo, giày dép cũng như nông cụ làm vườn. Nhằm mục đích tránh trường hợp vô tình phát tán nguồn bệnh.
Ngoài việc phải kiểm soát chuối giống thì bạn có thể sử dụng chế phẩm nấm Trichoderma để phòng ngừa bệnh vàng lá Panama ở cây chuối.
Cuối cùng, một biện pháp hiệu quả và tác dụng nhanh là sử dụng thuốc phòng ngừa côn trùng. Bạn có thể sử dụng thuốc…. Dù vậy, bạn vẫn có thể hoàn toàn yên tâm. Bởi loại thuốc này an toàn tuyệt đối với cây trồng và sức khỏe con người.
Hiện nay, nhiều nông dân áp dụng nhiều cách trị bệnh héo vàng chuối. Sau quá trình tổng hợp và kiểm tra thì ba cách sau là hiệu quả và có thể trị dứt điểm căn bệnh này nhanh nhất.

Cách trị bệnh chuối bị vàng lá
Đầu tiên, bạn có thể sử dụng các chế phẩm sinh học từ nấm Trichoderma. Mục đích ngăn chặn sự phát triển nấm, tuyến trùng gây hại trên cây chuối.
Giày dép, công cụ canh tác… có thể là nguồn lây lan bệnh vàng lá cây chuối. Vì vậy, bạn cần khử khuẩn thường xuyên. Nếu bạn đã ra vào vườn chuối bị bệnh thì phải khử khuẩn giày dép, quần áo và nông cụ ngay sau đó. Để tránh trường hợp lây lan sang vườn chuối khác.
Đồng thời, bạn phải thường xuyên kiểm tra để có thể chủ động nắm bắt tình hình phát triển bệnh. Nếu cây chuối trở bệnh quá nặng không có khả năng cho ra nông sản đạt chất lượng thì bạn nên chặt bỏ. Sau khi chặt bỏ, bạn nên gom cây chuối bệnh lại và tiêu hủy bằng cách đào hố rồi đốt. Trước khi đốt, bạn có thể rắc vôi bột hoặc trấu vào hố để khử khuẩn cho đất.
Ngoài ra, bạn có thể sử dụng bộ sản phẩm Rửa vườn, tẩy rong rêu địa y – Nano Đồng 500ml và Đặc trị nứt thân xỉ mủ, thối rễ – AT Anti Phytop 500ml. Mục đích nhằm rửa sạch vườn loại bỏ nguồn bệnh gây hại cây trồng. Đồng thời, bộ sản phẩm này có thể tiêu diệt nhanh chóng và dứt điểm các loại nấm gây hại.

Bộ sản phẩm phòng ngừa và tiêu diệt nấm bệnh gây vàng lá cây chuối
Nếu vườn chuối bị bệnh nghiêm trọng và buộc phải tiêu hủy thì bạn nên trồng các giống cây đối kháng. Bạn cũng có thể chuyển sang trồng giống chuối hoặc giống cây khác trong 2 – 3 năm.
Hy vọng với những thông tin trên có thể giúp bạn hiểu hơn về nguyên nhân, dấu hiệu cũng như cách phòng chống cây chuối bị bệnh vàng lá. Nếu muốn biết thêm thông tin về các sản phẩm được nhắc đến trong bài có thể liên hệ với hotline CÔNG TY TNHH CÔNG NGHỆ SẠCH NÔNG NGHIỆP: 09 622 41 635.
Giỏ hàng của bạn hiện tại chưa có sản phẩm nào.